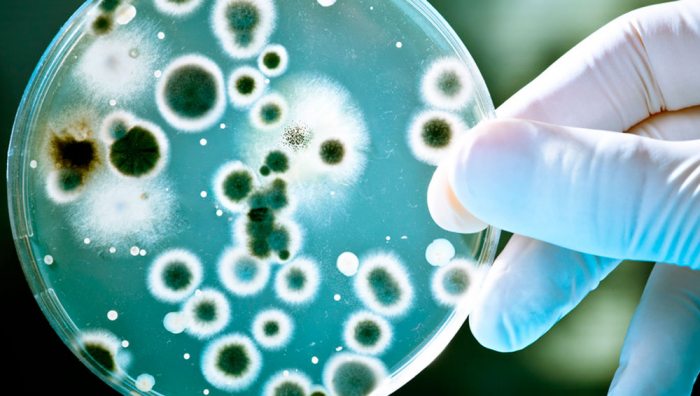

BIOLOGÍA
¿QUÉ ES LA BIOLOGÍA?
Según el biólogo francés Jean Baptiste de Lamarck, la biología estudia las células en función de su constitución molecular y la forma en que cooperan entre sí para constituir organismos muy complejos, como el ser humano. Pues deriva de los términos bio que significa vida, y logos que significa estudio; por lo que es la ciencia que estudia la vida.
¿QUÉ ES LA MICROBIOLOGÍA?
La microbiología es la rama de la biología que se encarga del estudio de los organismos microscópicos, deriva de tres palabras griegas “mikros” que significa pequeño, “bios” que significa vida y “logos” que significa estudio; por lo tanto, estas palabras en conjunto significan estudio de la vida microscópica. Estos seres pueden estar constituidos por una sola célula (unicelular), la cual puede ser eucariota como los hongos, procariotas como las bacterias, así como también estudia a los virus que son microscópicos pero no celulares.
TIPOS DE MICROBIOLOGÍA
El campo de la microbiología puede ser dividido en varias sub disciplinas:
FISIOLOGÍA MICROBIANA
Estudia a nivel bioquímico el funcionamiento de las células microbianas. Incluyendo el crecimiento, el metabolismo y la estructura microbiana.
GENÉTICA MICROBIANA
Estudia la organización y regulación de los genes microbianos y como estos afectan el funcionamiento de las células. Está muy relacionada con la biología molecular.
MICROBIOLOGÍA CLÍNICA
Estudia a todos los microorganismos que son causantes de patologías en los seres vivos.
MICROBIOLOGÍA MÉDICA
Estudia a los microorganismos causantes de patologías (enfermedades) humanas, por ejemplo: Estreptococo agalactiae que causa la sepsis (infección generalizada) en recién nacidos.
MICROBIOLOGÍA AMBIENTAL
Estudia la función y la diversidad de los microbios en sus entornos naturales. Incluyen la ecología microbiana, la geomicrobiología, la diversidad microbiana y la biorremediación.
MICROBIOLOGÍA VETERINARIA
Estudia a las bacterias y microbios que llegan a afectar directamente a los animales.
MICROBIOLOGÍA EVOLUTIVA
Estudia la evolución de los microbios. Incluyen la sistemática y la taxonomía bacterianas.
MICROBIOLOGÍA INDUSTRIAL
Estudia la explotación de los microbios para uso en procesos industriales. Son ejemplos: el tratamiento de aguas residuales y la fermentación industrial para la elaboración de cerveza o yogurt.
| Portada de HOY |
| 1 Dólar: | 6.96 Bs. |
| 1 Euro: | 8.08 Bs. |
| 1 UFV: | 2.26527 Bs. |
| Impunidad |